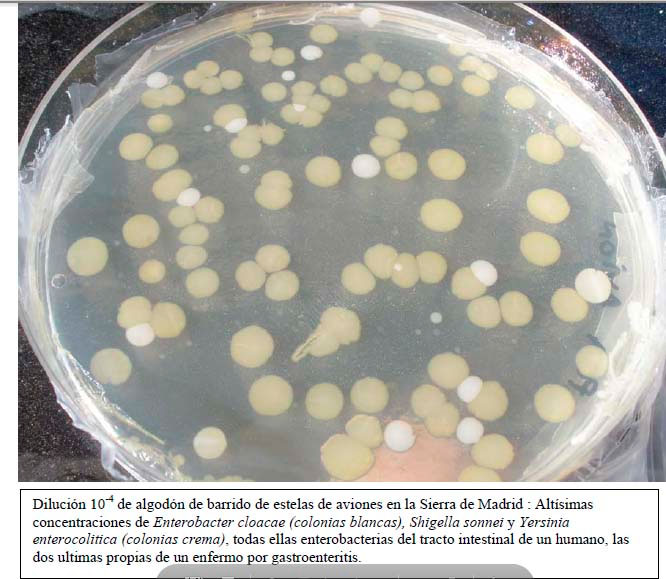
Muestra biológica de chemtrails

ПИРАМИДЫ, ХИМИОТРАСЛИ, ИНФЕКЦИОННЫЕ БАКТЕРИИ И БОЛЕЗНЬ МОРГЕЛЛОНОВ
АННОТАЦИЯ: Пирамиды могут помочь при болезни Моргеллонов, но мы не знаем, в какой степени их можно использовать для лечения после постановки диагноза на основании вещественных доказательств. Это наночастицы, поглощенные неизвестным образом (хотя многие утверждают, что это материал, занесенный якобы профилактическими прививками и вдыханием того, что выбрасывают самолеты). Обычно пирамидализованный организм выводит их быстрее, как это происходит со многими токсинами, избегая их накопления и последующей «сборки». Но как только тельца, вызывающие реакцию, собраны (эпителиальные или во внутренних органах), очень трудно узнать, может ли воздействие пирамидального поля растворить их как антилитическое средство, как это происходит с почечными и желчными камнями (литиаз или как его еще называют). действует с пирамидой с элементами ревматизма, растворяя кристаллы мочевой кислоты). Что касается инфекций, вызванных бактериями, распыляемыми химтрейлами, то их можно предотвратить, но вызываемые ими заболевания также можно вылечить (и даже гангрену или сепсис, как мы уже добились с помощью соответствующих пирамид).
В этом разделе рассматривается проблема, имеющая очень серьезные политические последствия, поэтому на нее нет заметных ссылок с остальной части сайта. Мы не намерены создавать ложные ожидания, но мы знаем, что пирамиды содержат возможные профилактические решения для болезни Моргеллонов, а также профилактику и радикальное лечение бактерий, которые также распространяются химтрейлами.
Мы не лечили ни одного случая с пирамидами, который был бы диагностирован как болезнь Моргеллонов, но мы лечили все виды бактерий, включая те, которые появляются при анализе материала, собранного после конденсации и осаждения веществ, фумигированных с помощью «химтрейлов» или химических веществ. тропы, как можно увидеть на изображениях ниже. Также были вылечены редкие случаи начальных проблем с кожей, которые «могли быть синдромом Моргеллонов», но благодаря оптимизации иммунной системы, а также всех функций органических жидкостей благодаря пирамидальному эффекту наночастицы устраняются до того, как они собираются. производят «волокна», подобные тем, что показаны на этих изображениях, собранных в Интернете. И мы искренне надеемся, что никогда не услышим ни о каком подобном случае.
Диета, богатая растительной клетчаткой (особенно клетчаткой из фруктов и зеленых листьев, таких как салат, эндивий, цикорий, сырой шпинат, эскариоль и кресс-салат), по многим причинам является наиболее подходящей пищей для противодействия и профилактики синдрома Моргеллонов (также известного как болезнь Моргеллонов). , моргеллоны или моргеллоны). На Кубе, где проводились самые массовые и методичные испытания пирамидального эффекта (который и по сей день применяется практически во всех больницах и клиниках страны), на десятках тысяч пациентов с различными заболеваниями, особенно ортопедическими, травматологическими и ревматизм, только До 2008 года... Химиотрасс не было. Случаи заболевания болезнью Моргеллонов не известны, поэтому у нас не было возможности лечить кого-либо с такими симптомами. За 20 дней, которые я читал лекции в Пинар-дель-Рио, Камагуэе, Сьенфуэгосе и больше недели в Гаване, мы не увидели ни одной из тех троп, которые мы видим в Испании, Франции и Португалии. Мы не видели их в Венесуэле или Египте, но видели в Колумбии. Это очень любопытно, потому что погодные условия очень похожи, а регулярные рейсы ОДИНАКОВЫЕ. Те же авиакомпании. Но ни одного из серых самолетов без опознавательных знаков, засоряющих европейское небо химтрейлами, не видно.

Доктор ХИЛЬДЕГАРД СТАНИНГЕР
Доктор Хильдегарда Станингер из Лос-Анджелеса — один из авторитетных ученых, наиболее полно исследовавших болезнь Моргеллонов. Согласно его окончательным и неоспоримым подтверждениям, сопоставленным группой Osiris с другими исследователями и сотрудниками, статистические выводы этого синдрома таковы:
- В 2008 году в США было зарегистрировано более 60 000 случаев заболевания, а во всем мире — 100 000, при этом ежедневно число случаев заболевания во всем мире увеличивалось на тысячу. По данным доктора Х. Станингера, на Калифорнию, Техас и Флориду приходится 26%. Но по данным других авторов, в штате Оклахома наблюдается более значительный рост, чем в остальной части страны, и в настоящее время он превосходит остальной мир, по крайней мере до конца 2011 года. Очень печальные сообщения поступают из Африки, но только от некоторых социальных волонтеров. , без подтверждения со стороны какого-либо правительства. На изображениях — микроволокна, вызывающие болезнь Моргеллонов. Самые тонкие нити имеют толщину от одного до 20 нанометров, или миллионных долей миллиметра. Его сопротивление равно или превышает сопротивление паутины, однако пучки волокон могут достигать размера, приближающегося к половине человеческого волоса.
ПОДРОБНОСТИ БОЛЕЗНИ МОРГЕЛЛОНА (или morgellon)
ФИЗИЧЕСКИЕ СИМПТОМЫ
- Кожная сыпь, похожая на ветряную оспу, оспу или на укусы насекомых.
- Покалывание, боль, жжение, покалывание и небольшие ощущения от укусов под кожей.
- Под кожей появляются синие, белые, черные и красные волокна и гранулы, иногда скапливающиеся в виде морщин.
- Постоянная усталость, ощущение «наличия кристаллов» под кожей, а иногда и в разных частях тела.
ПСИХОЛОГИЧЕСКИЕ И МЕНТАЛЬНЫЕ СИМПТОМЫ
- Потеря памяти.
- Нарушения внимания, потеря самоконтроля, неспособность рассуждать и обсессивно-компульсивное расстройство.
- Чувство изоляции, депрессии и эмоционального стресса.
- Многим пациентам с болезнью Моргеллонов ошибочно ставят диагноз «бредовый паразитоз», компульсивный зуд или расчесывание, как будто это психопатология. Я лечил около пяти тысяч пациентов в кабинетах клинической психологии и глубоко изучил все официальные и альтернативные психологические школы, но ни разу не встречал психопатии с такими характеристиками, и еще меньше с физическими признаками, подобными тем, что предъявляют люди, страдающие болезнью Моргеллонов. Наиболее близким к этому является навязчивое желание самоистязания, которое я наблюдал у пациента с суицидальными инграммами из детства.
Говоря очень прозаичным языком, согласно психиатрии, если вы много чешетесь, потому что чувствуете, что зуд слишком сильный, и получаете ожоги, которые идут ПОД кожей, это происходит не потому, что на коже есть что-то материальное, а потому, что вы сумасшедший, ненормальный, одержимый, с «биполярным расстройством»... Или нервные окончания, составляющие вашу периферическую нервную систему, сошли с ума, согласно современной психопатологической классификации. Затем вам дают лекарства, содержащие литий и другие металлы...
ГРУППА НАСЕЛЕНИЯ
- Заболевание может поразить как одного члена семьи, так и всех, при отсутствии в семейном анамнезе подобных заболеваний.
- Заболевание поражает людей любого возраста, от детей до пожилых людей, и симптомы у них одинаковые.
Большинство смертей до 2011 года (в основном из-за печеночной недостаточности), хотя эти цифры неофициальны и я не могу их назвать, пока не получу твердого подтверждения, сосредоточены в США, Англии и Голландии. Наиболее важные центры расположены на юго-востоке США и в Оклахоме.
РЕШЕНИЯ, которые мы можем предложить, профилактические в случае болезни Моргеллонов и лечебные с большей безопасностью в случае бактериальной атаки (в зависимости от интенсивности бактериальной нагрузки), заключаются в использовании спящих пирамид в сочетании с лечением ХЕЛАТООБРАЗОВАНИЕМ (глубокое очистка от тяжелых металлов и микроскопических инородных тел). Подробнее об этом можно прочитать в Telegram-канале t.me/medicinareal на испанском языке. Восемь часов в день (или все время, если хотите) в алюминиевой пирамиде высокой чистоты с правильными характеристиками плотности очень быстро оптимизируют кровеносную и лимфатическую системы, так что через несколько недель все вещества в организме будут удалены. с собственными молекулами поверхностно-активных веществ. Это приводит к ускорению всех органических функций, способствуя устранению всех чужеродных агентов. Для болезни Моргеллонов характерно то, что она не вызывает реакции со стороны иммунной системы, но не препятствует действию фагов, которые распознают наночастицы как «объекты», не принадлежащие организму. Антибиотики также не действуют ни на одном участке спектра, а некоторые кортикостероиды обеспечивают лишь временное облегчение, побочные эффекты которых столь же опасны, как и сам синдром Моргеллонов. Пирамида производит оптимизацию органических жидкостей и в конечном итоге всех молекул, так что большая часть любого вещества, которое не соответствует телу, легче выводится, при условии, что его размер не достиг пропорций, позволяющих ему «закрепиться» за каким-то клетки.
В качестве превентивной меры в местах, где облака химтрейлов не оказывают большого воздействия, может быть достаточно Piramicama, но там, где распыление интенсивное, Hercules более уместен и безопасен, так как он примерно в четыре раза мощнее с точки зрения органических процессов. .
Самое неприятное происходит, когда у субъекта кристаллы уже преобразованы в прочные полимерные волокна, подобные пластиковому кабелю. Получить больше информации об этих угрозах, которые сегодня наиболее опасны, но от которых мы можем защититься, можно только путем формирования Народных собраний. Другая угроза, избежать которой мы можем только путем захвата власти во всех странах народом через АССАМБЛЕИ, — это HAARP, о котором в Интернете есть тысячи упоминаний. Видео ниже и ссылки отсылают нас к наиболее авторитетному объяснению, которое существует на данный момент, тем более, что оно исходит из Лос-Анджелеса, то есть из США, где население подвергается наиболее интенсивной дезинфекции.
Волосы, образующие волокна Моргеллонов, не обладают нормальной электростатикой. Если вы поместите палец на расстоянии нескольких миллиметров, они не отреагируют таким же образом, но останутся невосприимчивыми к эпидермальной электростатике, как со стороны пациента, так и со стороны другого субъекта, что демонстрирует принципиальное отличие от биологических волос. Это свидетельствует о том, что в волокнах Моргеллонов присутствует электропроводность, нетипичная для человеческих волос. Волосы реагируют, потому что у них есть электростатика, то есть очень низкая электропроводность. Это не означает, что существует большая разница между тремя магнитными состояниями (ферро, диа и парамагнетизм), а скорее более высокая электропроводность, вызванная переходными элементами, такими как железо, титан, никель и другими (группа «d " в периодической таблице Менделеева).
Третья часть анализируемых компонентов — молекулы полиэфира. Недавно были обнаружены даже кристаллы полиэстера, такие как жидкий полиэстер. Было показано, что компоненты, выделенные доктором Хильдегардой Станингер и другими учеными, имеют pH 10 или выше, что можно обнаружить только в кишечнике, желудке или печени, что указывает на то, что, имея это органическое сродство, в дополнение к сопротивлению атаке Кислота, попадая на кожу, буквально и моментально «обжигает», что объясняет большую часть симптоматики, которую некоторые скептически настроенные психиатры называют «обсессивно-компульсивным зудом». Моргеллоны в конечном итоге обнаруживаются в периферической нервной системе, где расположены нервные окончания, отвечающие за тактильные ощущения (и боль).
Волокна состоят из частиц настолько малых размеров, что их размер составляет от одной миллионной доли миллиметра, то есть от нанометра до примерно двадцати нанометров. Они соединены между собой другими частицами, называемыми наноассемблеры... Нанороботы, которые перемещаются в определенные области с помощью химического, магнитного или электрического сродства и присоединяются к одноименным частицам, образуя таким образом волокна, которые затем группируются в жгуты, подобно кабелю. Приблизительный механизм состоит из совокупности компонентов, которые, однажды сформировавшись в своей базовой структуре, могут питаться энергией, вырабатываемой собственными клетками организма.
Некоторые из этих волокон горят при температуре 315 ºC, а другие, изготовленные из полиэстера и других органических соединений, золота и кремния, выдерживают температуру до 760 ºC.
Самая серьезная проблема заключается в том, что когда болезнь проявляется на коже, имеются физические доказательства и даже поставлен «психиатрический» диагноз, никто не может сказать, в какой степени заражены внутренние органы, поэтому может быть вызвано столько смертей. Моргеллоны, даже если их диагностировали как любую другую болезнь.
Не нужно бояться заражения, по крайней мере, при контакте с больным человеком, потому что это не естественный паразит, он не размножается, он не биологический, а искусственный, он производится земными лабораториями, с помощью земных технологий, с помощью соединений. уже широко используется в электронике и нанотехнологиях.
ДРУГАЯ ПРОБЛЕМА – это распыление биологических химтрейлов. Он подразумевает распыление больших объемов биологического материала, который может быть обработан или «доработан» с помощью нанотехнологий, а может и нет. Но что касается бактериальной проблемы, то здесь мы с полной уверенностью можем решить ее с помощью пирамид, по крайней мере, в их обычных формах, даже если это чрезвычайно серьезная инфекция, такая как септицемия или гангрена. Ниже вы можете ознакомиться с изображениями биологического отчета по образцам, собранным в горах Сьерра-де-Гвадаррама в сентябре 2009 года. Этот документ использовался для подачи жалоб по всей Испании и за рубежом. Ни один судья не соизволил рассмотреть это дело, в котором, если бы была хоть какая-то справедливость, то потерпевшие должны были бы, по крайней мере, оказаться в тюрьме за разжигание паники. Они даже не захотели получать соответствующие файлы.
При детальном исследовании образцов молекулярный анализ не проводился, поэтому нельзя было исключить наличие веществ, которые впоследствии могли бы вызвать болезнь Моргеллонов. При желании вы можете скачать документ в формате PDF.
ПЕРЕВОД ДОКУМЕНТА:
ОТЧЕТ О МИКРОБИОЛОГИЧЕСКОМ АНАЛИЗАХ 4 образцов дисперсных природных поверхностей, полученных в горах Сьерра-де-Гвадаррама 3 июля 2009 года и взятых с хлопка. Образцы из химтрейлов.
1.- Хлопок 1: Избыток кишечных энтеробактерий (>10 (5) КОЕ/образец с почти исключительным присутствием ENTEROBACTER CLOACAE (кремовый цвет толстой кишки на приложенном фото в PCA). Возможные выделения из бачков туалета самолета? Но любопытно отсутствие E. Coli. Это была бы самая распространенная бактерия, если бы ее сбрасывали в человеческие туалеты.
2.- Хлопок 2. Избыток кишечных энтеробактерий (количество аналогично предыдущему) с почти исключительным присутствием Enterobacter cloacae и вторично Shigella sonnei и Yersinia enterocolitica. Можно ли смыть бачок унитаза человеку, страдающему гастроэнтеритом? Но вот с любопытным отсутствием Enterobacter Coli. Это были бы самые распространенные бактерии, если бы это были стоки из сливного бачка человеческого туалета.
3.- Хлопок 3: Избыток кишечных энтеробактерий (как указано выше) и вторично Shigella sonnei. Возможно ли смыв бачков унитаза у человека с гастроэнтеритом? Но вот с любопытным отсутствием Enterobacter Col. Это была бы самая распространенная бактерия, если бы это были сливные бачки человеческих туалетов.
4.- Хлопок 4: Избыток кишечных энтеробактерий (как указано выше) и вторично Yersinia enterocolitica. Возможно ли смыв бачков унитаза у человека с гастроэнтеритом? Но вот с любопытным отсутствием Enterobacter Coli. Это были бы самые распространенные бактерии, если бы это были стоки из сливного бачка человеческого туалета.
ПРИМЕЧАНИЯ И ВЫВОДЫ:
Во всех случаях наблюдается очень высокая концентрация грамотрицательных и факультативно ферментирующих бактерий, средой обитания которых является кишечный тракт. Доминирующим видом во всех четырех случаях является Enterobacter cloacae. Однако поразительно, что пропорции между видами ни в коем случае не соответствуют тем, которые можно было бы ожидать в кишечном тракте здорового человека, где более 95% кишечной флоры составляют Enterobacter coli. Однако в образцах этот вид даже не появляется.
Мы не можем сделать окончательных выводов о фактическом происхождении образцов, но следует сказать, что они не соответствуют здоровой естественной среде обитания. И еще меньше их было в саду и в горах Сьерра-де-Мадрид.
Подписано биологом Хорхе Санчисом Солерой 21 сентября 2009 г.
Сертифицированный биолог 02573.-C
ИНФОРМАЦИЯ О ХИМТРЕЙЛАХ И МОРГЕЛЛОНАХ
В этом видео с субтитрами на испанском языке мы можем увидеть из первых уст заявления эксперта в области промышленной токсикологии, доктора Хильдегарды Станингер.
ПОМОГИТЕ ДОБИТЬСЯ ОДОБРЕНИЯ ПИРАМИДОТЕРАПИИ

Piramicasa :Gabriel-Silva: Piramicasa.